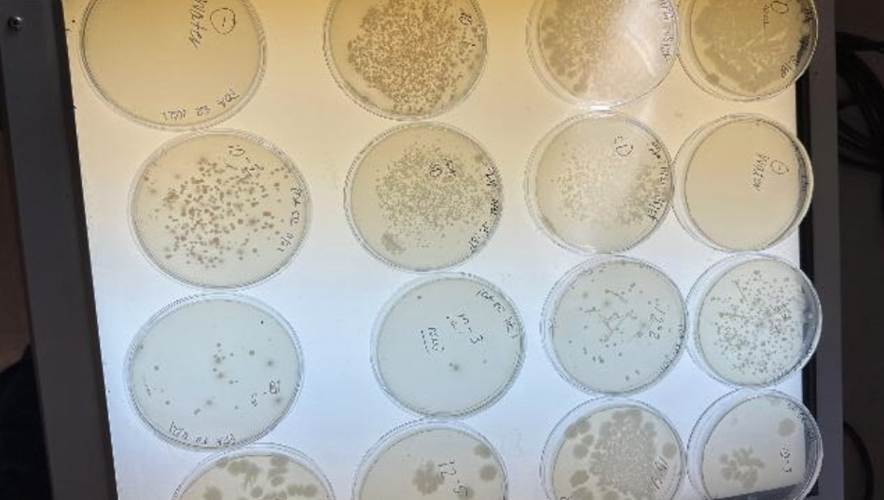
Quantification of Viability

Country
United States of America US Virgin Islands United States Minor Outlying Islands Canada Mexico, United Mexican States Bahamas, Commonwealth of the Cuba, Republic of Dominican Republic Haiti, Republic of Jamaica Afghanistan Albania, People's Socialist Republic of Algeria, People's Democratic Republic of American Samoa Andorra, Principality of Angola, Republic of Anguilla Antarctica (the territory South of 60 deg S) Antigua and Barbuda Argentina, Argentine Republic Armenia Aruba Australia, Commonwealth of Austria, Republic of Azerbaijan, Republic of Bahrain, Kingdom of Bangladesh, People's Republic of Barbados Belarus Belgium, Kingdom of Belize Benin, People's Republic of Bermuda Bhutan, Kingdom of Bolivia, Republic of Bosnia and Herzegovina Botswana, Republic of Bouvet Island (Bouvetoya) Brazil, Federative Republic of British Indian Ocean Territory (Chagos Archipelago) British Virgin Islands Brunei Darussalam Bulgaria, People's Republic of Burkina Faso Burundi, Republic of Cambodia, Kingdom of Cameroon, United Republic of Cape Verde, Republic of Cayman Islands Central African Republic Chad, Republic of Chile, Republic of China, People's Republic of Christmas Island Cocos (Keeling) Islands Colombia, Republic of Comoros, Union of the Congo, Democratic Republic of Congo, People's Republic of Cook Islands Costa Rica, Republic of Cote D'Ivoire, Ivory Coast, Republic of the Cyprus, Republic of Czech Republic Denmark, Kingdom of Djibouti, Republic of Dominica, Commonwealth of Ecuador, Republic of Egypt, Arab Republic of El Salvador, Republic of Equatorial Guinea, Republic of Eritrea Estonia Ethiopia Faeroe Islands Falkland Islands (Malvinas) Fiji, Republic of the Fiji Islands Finland, Republic of France, French Republic French Guiana French Polynesia French Southern Territories Gabon, Gabonese Republic Gambia, Republic of the Georgia Germany Ghana, Republic of Gibraltar Greece, Hellenic Republic Greenland Grenada Guadaloupe Guam Guatemala, Republic of Guinea, Revolutionary
People's Rep'c of Guinea-Bissau, Republic of Guyana, Republic of Heard and McDonald Islands Holy See (Vatican City State) Honduras, Republic of Hong Kong, Special Administrative Region of China Hrvatska (Croatia) Hungary, Hungarian People's Republic Iceland, Republic of India, Republic of Indonesia, Republic of Iran, Islamic Republic of Iraq, Republic of Ireland Israel, State of Italy, Italian Republic Japan Jordan, Hashemite Kingdom of Kazakhstan, Republic of Kenya, Republic of Kiribati, Republic of Korea, Democratic People's Republic of Korea, Republic of Kuwait, State of Kyrgyz Republic Lao People's Democratic Republic Latvia Lebanon, Lebanese Republic Lesotho, Kingdom of Liberia, Republic of Libyan Arab Jamahiriya Liechtenstein, Principality of Lithuania Luxembourg, Grand Duchy of Macao, Special Administrative Region of China Macedonia, the former Yugoslav Republic of Madagascar, Republic of Malawi, Republic of Malaysia Maldives, Republic of Mali, Republic of Malta, Republic of Marshall Islands Martinique Mauritania, Islamic Republic of Mauritius Mayotte Micronesia, Federated States of Moldova, Republic of Monaco, Principality of Mongolia, Mongolian People's Republic Montserrat Morocco, Kingdom of Mozambique, People's Republic of Myanmar Namibia Nauru, Republic of Nepal, Kingdom of Netherlands Antilles Netherlands, Kingdom of the New Caledonia New Zealand Nicaragua, Republic of Niger, Republic of the Nigeria, Federal Republic of Niue, Republic of Norfolk Island Northern Mariana Islands Norway, Kingdom of Oman, Sultanate of Pakistan, Islamic Republic of Palau Palestinian Territory, Occupied Panama, Republic of Papua New Guinea Paraguay, Republic of Peru, Republic of Philippines, Republic of the Pitcairn Island Poland, Polish People's Republic Portugal, Portuguese Republic Puerto Rico Qatar, State of Reunion Romania, Socialist Republic of Russian Federation Rwanda, Rwandese Republic Samoa, Independent State of San Marino, Republic of Sao Tome and Principe, Democratic Republic of Saudi Arabia, Kingdom of Senegal, Republic of Serbia and Montenegro Seychelles, Republic of Sierra Leone, Republic of Singapore, Republic of Slovakia (Slovak Republic) Slovenia Solomon Islands Somalia, Somali Republic South Africa, Republic of South Georgia and the South Sandwich Islands Spain, Spanish State Sri Lanka, Democratic Socialist Republic of St. Helena St. Kitts and Nevis St. Lucia St. Pierre and Miquelon St. Vincent and the Grenadines Sudan, Democratic Republic of the Suriname, Republic of Svalbard & Jan Mayen Islands Swaziland, Kingdom of Sweden, Kingdom of Switzerland, Swiss Confederation Syrian Arab Republic Taiwan, Province of China Tajikistan Tanzania, United Republic of Thailand, Kingdom of Timor-Leste, Democratic Republic of Togo, Togolese Republic Tokelau (Tokelau Islands) Tonga, Kingdom of Trinidad and Tobago, Republic of Tunisia, Republic of Turkey, Republic of Turkmenistan Turks and Caicos Islands Tuvalu Uganda, Republic of Ukraine United Arab Emirates United Kingdom of Great Britain & N. Ireland Uruguay, Eastern Republic of Uzbekistan Vanuatu Venezuela, Bolivarian Republic of Viet Nam, Socialist Republic of Wallis and Futuna Islands Western Sahara Yemen Zambia, Republic of Zimbabwe